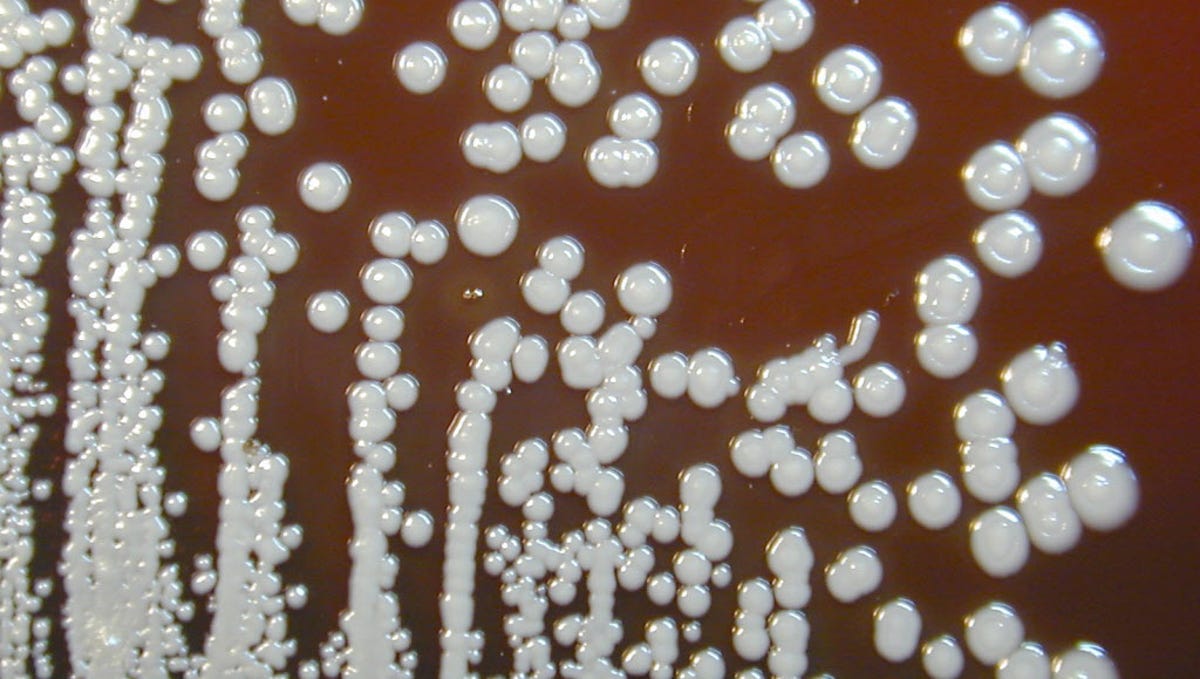

Top Scientist Warns of Potential Pandemic Threat from 'Deranged Loner'
Lord Rees, a prominent scientist, warned that a "deranged loner" could unleash a pandemic using easily accessible biotech expertise and off-the-shelf equipment, emphasizing the increasing availability of laboratories, equipment, and expertise globally. He urged for enhanced security and independent monitoring of level four labs researching lethal pathogens, and cautioned that the world is unprepared for the moral and practical challenges posed by the growing empowerment of malign, tech-savvy groups in biotech.